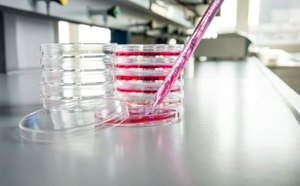
Albumin Promotion Albumin Promotion

Promotions, Savings and Samples
Explore a variety of exciting offers designed to enhance your research. Our Promotions Hub features valuable opportunities to support your scientific endeavors, such as promotional discounts, customer savings program or sample and demo offers.
Promotions
25% off our Supelco Vials with Promo Code G59
Valid until 31 December 2025
We're thrilled to offer you access to our seasonal specials offer filled with product discount offers, gaming, and surprises.
Check out our current offers on Labware Essentials!
Valid until 31 December 2025
Valid until 30 November 2025 with the promo code IIS
Limited-time deal on media, vials and more! Use promo code IIH at checkout.
Offer expires on 31 December 2025
Try our new single-dose antibiotics at a special 20% discount, or unlock 35% off our entire portfolio with promo code III. Hurry, offer ends December 31!
Rock this Limited-Time Jam and Save 30%.
Promotion Code: IHW
Valid until 31 December 2025
Apply promo code III to your order at checkout.
Valid until 31 December 2025
For a limited time, enjoy a 25% discount with Promotion Code: IHV
Valid until 31 December 2025
Spark your research journey with our special discounts!
Promotion Code: IGQ
Valid until 31 December 2025
Complete the short form and receive your 30% discount when purchasing KOD One™ PCR Master Mix.
Valid until 31 December 2025
Save big with promo code: IFW
Valid until 31 December 2025
Contact your local sales specialist
Valid until 31 December 2025
Your Pathway to Savings on Bioactive Small Molecules and Signaling Proteins
Use Promotion Code: IEW
Valid until 31 December 2025
Enjoy a 25% discount across our entire antibody portfolio.
Use Promotion Code: IHO until 31 December 2025
Customer Savings Programs
Sign up today, share your list of project needs and receive your welcome pack!
Let us help your research flourish.
Valid until 31 December 2025
Request your competitive pricing for chemical synthesis now to receive your exclusive pin.
Discover all the ways we can accelerate
your path to launching your next
pioneering drug therapy.
Product Samples and Demos
Explore interactive demos of our advanced devices—ready to streamline your lab routine and help you work smarter!
Experience personalized demonstrations of our cutting-edge chemical synthesis instruments.
Experience the benefits of our optimized cell culture media for yourself - Request your free sample.
Valid until 31 December 2025
Experience the benefits of Millipore Express® filters for yourself today- Request your free sample.
Our offer expires 28 February 2026
Experience the benefits of Pellicon® 3 cassettes for yourself - Request your free sample.
Our offer expires 28 February 2026
Experience the benefits of Viresolve® Pro Solution for yourself today - Request your free sample.
Our offer expires on Feb. 28, 2026
Experience the efficiency of Multiscreen® Filter Plates and streamline your processes. Request your sample today!
Get your complimentary bottle each of our Aquastar® Karl Fischer Titration Reagents, Solvents, and Standards to test their suitability in your application.
Discounted samples to support your sample raw material needs for assay suitability.
Get your sample now to achieve DNA and RNA preparations with fewer impurities for more robust results!
Save time, effort, and shelf space with pHast pack™ ready-to-use buffers.
No weighing, calculations, or pH adjustments required.
Suitable Millex® syringe filters and polypropylene Membranes.
Supelclean™ ENVI-WAX SPE for PFAS analysis.
Other interesting content you might find useful
Your go-to destination for everything pins!
Discover the Magic Inside our newsletters and receive a free Lab Coat Pin.
Discover our Neuroscience Hub with cutting-edge products, expertise and global research wisdom to unlock the secrets of neural networks!
This Scientific hub for Cancer Research will help you to find info on Products / Solutions, Technical Resources, Webinars and Brochures.
We are committed to sharing our technical expertise and supporting your science through our Seminar Program.
*Offers valid throughout the validity period stated. Certain restrictions apply. Offers do not apply to products sold through Merck dealers or to customers with contracts in place. Certain offers may not be valid in all geographic regions; sample quantities may be limited, additional restrictions may apply - please contact your local office for information specific to your region. Merck reserves the right to modify or terminate these or any other promotions at any time in its sole discretion.
To continue reading please sign in or create an account.
Don't Have An Account?